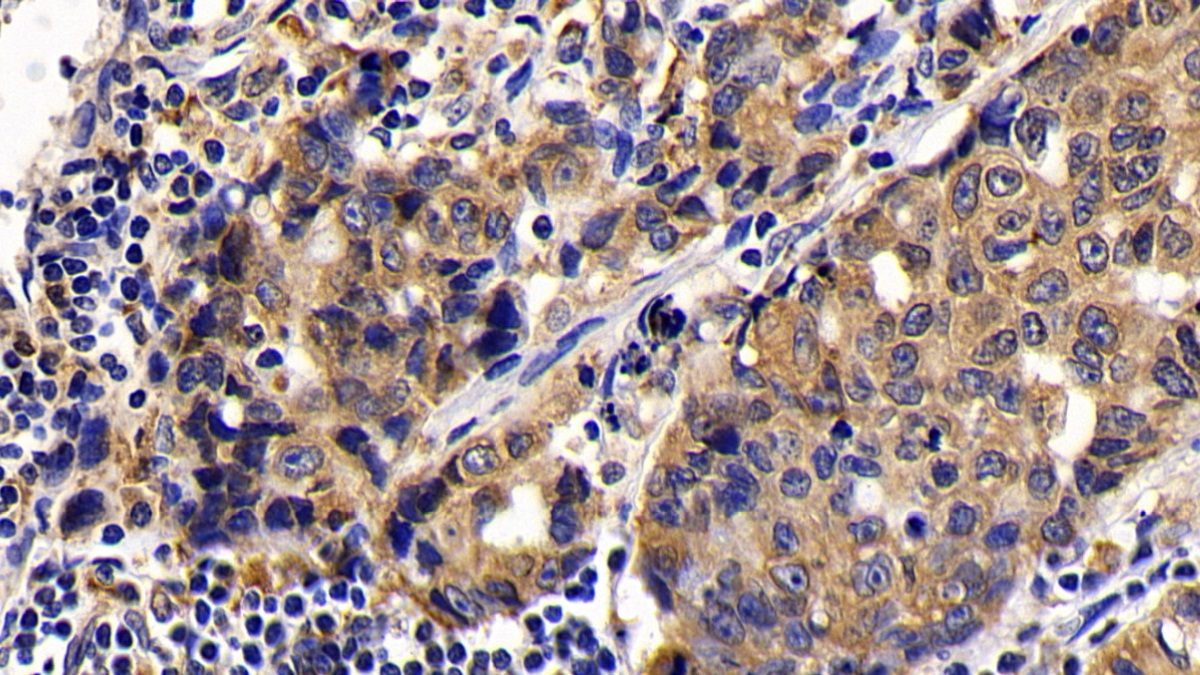

Monoclonal Antibody to B-Cell Leukemia/Lymphoma 2 (Bcl2) 

B-Cell CLL/Lymphoma 2
Overview
Properties
- Product No.MAA778Hu21
- Organism SpeciesHomo sapiens (Human) Same name, Different species.
- ApplicationsIHC; ICC/IF
If the antibody is used in flow cytometry, please check FCM antibodies.
Research use only - DownloadInstruction Manual
- CategorySignal transductionApoptosis
- SourceMonoclonal antibody preparation, Host Mouse
- Ig Isotype IgG1 Kappa, Clone Number D6
- PurificationProtein A + Protein G affinity chromatography
- LabelNone
- Immunogen RPA778Hu01-Recombinant B-Cell Leukemia/Lymphoma 2 (Bcl2)
- Buffer FormulationPBS, pH7.4, containing 0.02% NaN3, 50% glycerol.
- TraitsLiquid, Concentration 1mg/mL
Sign into your account
Share a new citation as an author
Upload your experimental result
Review

Contact us
Please fill in the blank.
Specifity
The antibody is a mouse monoclonal antibody raised against Bcl2. It has been selected for its ability to recognize Bcl2 in immunohistochemical staining and western blotting.
Usage
Western blotting: 0.01-3µg/mL;
Immunohistochemistry: 5-30µg/mL;
Immunocytochemistry: 5-30µg/mL;
Optimal working dilutions must be determined by end user.
Storage
Store at 4°C for frequent use. Stored at -20°C in a manual defrost freezer for two year without detectable loss of activity. Avoid repeated freeze-thaw cycles.
Stability
The thermal stability is described by the loss rate. The loss rate was determined by accelerated thermal degradation test, that is, incubate the protein at 37°C for 48h, and no obvious degradation and precipitation were observed. The loss rate is less than 5% within the expiration date under appropriate storage condition.
Organism Species More: Sus scrofa; Porcine (Pig)Giveaways
Increment services
-
 Antibody Labeling Customized Service
Antibody Labeling Customized Service
-
 Protein A/G Purification Column
Protein A/G Purification Column
-
 Staining Solution for Cells and Tissue
Staining Solution for Cells and Tissue
-
 Positive Control for Antibody
Positive Control for Antibody
-
 Tissue/Sections Customized Service
Tissue/Sections Customized Service
-
 Phosphorylated Antibody Customized Service
Phosphorylated Antibody Customized Service
-
 Western Blot (WB) Experiment Service
Western Blot (WB) Experiment Service
-
 Immunohistochemistry (IHC) Experiment Service
Immunohistochemistry (IHC) Experiment Service
-
 Immunocytochemistry (ICC) Experiment Service
Immunocytochemistry (ICC) Experiment Service
-
 Flow Cytometry (FCM) Experiment Service
Flow Cytometry (FCM) Experiment Service
-
 Immunoprecipitation (IP) Experiment Service
Immunoprecipitation (IP) Experiment Service
-
 Immunofluorescence (IF) Experiment Service
Immunofluorescence (IF) Experiment Service
-
 Buffer
Buffer
-
 DAB Chromogen Kit
DAB Chromogen Kit
-
 SABC Kit
SABC Kit
-
 Long-arm Biotin Labeling Kit
Long-arm Biotin Labeling Kit
-
 Real Time PCR Experimental Service
Real Time PCR Experimental Service
Citations
- Analysis of p53 and miRNA expression after irradiation of glioblastoma cell linesPubMed: 23155233
- Neurotoxic effect of lead on rats: Relationship to ApoptosisNCBI: PMC3883608
- Effects of hepatocyte growth factor in myocarditis rats induced by immunization with porcine cardiac myosinPubmed: 24327573
- Vitamin D ameliorates hepatic ischemic/reperfusion injury in ratsPubmed:24752458
- Gastroprotective effect of nymphayol isolated from Nymphaea stellata (Willd.) flowers: Contribution of antioxidant, anti-inflammatory and anti-apoptotic activitiesPubmed:25289771
- Serum Bcl-2 Values in Children with Pulmonary HypertensionPubmed:25381623
- Inhibition of small HA fragment activity and stimulation of A2A adenosine receptor pathway limit apoptosis and reduce cartilage damage in experimental arthritisPubmed:25511416
- Mangiferin Mitigates Gastric Ulcer in Ischemia/ Reperfused Rats: Involvement of PPAR-γ, NF-κB and Nrf2/HO-1 Signaling PathwaysPubMed: 26196679
- Protective Effect of Oral Hesperetin Against Unilateral Striatal 6-Hydroxydopamine Damage in the RatPubMed: 26700436
- Hepatoprotective Effects of Rubus idaeus L. Leaves against CCl4-Induced Liver Injury via Antioxidant, Anti-inflammatory and Antiapoptotic Mechanismsopenview:626440
- THE PROPHYLACTIC EFFICIENCY OF LYCOPENE AGAINST GAMMA IRRADAITION-INDIUCED CARDIAC OXIDATIVE DAMAGE, PATHOLOGY AND APOPTOSIS IN RATSpublication:298838934
- Neuroprotective Effect of Nanodiamond in Alzheimer's Disease Rat Model: a Pivotal Role for Modulating NF-κB and STAT3 SignalingPubmed:26897372
- The ameliorative potential of ethanolic extract of propolis on hematotoxicity and structural neuronal damage in hyperthermia-exposed ratspubmed:27746870
- In Vivo Characterization of ARN14140, a Memantine/Galantamine-Based Multi-Target Compound for Alzheimer's Diseasepubmed:27609215
- An Intranasal Formulation of Erythropoietin (Neuro-EPO) Prevents Memory Deficits and Amyloid Toxicity in the APPSwe Transgenic Mouse Model of Alzheimer's …articles:journal-of-alzheimers-disease
- Amelioration of cardiac dysfunction and ventricular remodeling after myocardial infarction bydanhong injection are critically contributed by anti-TGF-β-mediated fibrosis and angiogenesis mechanisms.pubmed:27729285
- Mangiferin protects against intestinal ischemia/reperfusion-induced liver injury: Involvement of PPAR- γ, GSK-3β and Wnt/β-catenin pathwaypubmed:28506911
- Comparative Effects of Stevia rebaudiana and Aspartame on hepato-renal function of diabetic rats: Biochemical and Histological Approaches59b5141c458515a5b49377cf
- A Novel Role of SIRT1/ FGF-21 in Taurine Protection Against Cafeteria Diet-Induced Steatohepatitis in Ratspubmed:28942443
- Mechanistic insights into the effects of quercetin and/or GLP-1 analogue liraglutide on high-fat diet/streptozotocin-induced type 2 diabetes in ratspubmed:28554128
- Distinctive expression signatures of serum microRNAs in ischaemic stroke and transient ischaemic attack patientspubmed:28251236
- A polysaccharide (PNPA) from Pleurotus nebrodensis ameliorates hepatic ischemic/reperfusion (I/R) injury in ratspubmed:28709897
- Neuroprotective Effect of Nanodiamond in Alzheimer’s Disease Rat Model: a Pivotal Role for Modulating NF-κB and STAT3 Signalingpubmed:26897372
- Potentiation of Apoptosis in Rat Striatum Exposed to Endosulfan and the Role of Quercetin10.1007/s13530-017-0325-1
- Cardioprotective effect of the xanthones from Gentianella acuta against myocardial ischemia/reperfusion injury in isolated rat heartpubmed:28686977
- Association of Bax and Bcl-2 Functional Polymorphisms and Protein Levels with Posttraumatic Stress DisorderpaperID:82598
- Structural optimization and additional targets identification of antisense oligonucleotide G3139 encapsulated in a neutral cytidinyl-lipid combined with a cationic lipid …Pubmed: 30660994
- Taxifolin protects rat against myocardial ischemia/reperfusion injury by modulating the mitochondrial apoptosis pathwayPubmed: 30723634
- INSTITUTO DE CIENCIAS BÁSICAS Y PRECLÍNICAS “VICTORIA DE GIRÓN” DEPARTAMENTO DE HISTOLOGÍA
- Neuroprotection in non-transgenic and transgenic mouse models of Alzheimer's disease by positive modulation of σ1 receptorsPubmed: 31048034
- Metallothionein-1 is associated with osteoarthritis disease activity and suppresses proinflammatory cytokines production in synovial cellsPubmed: 31465913
- LncRNA SNHG3 promotes clear cell renal cell carcinoma proliferation and migration by upregulating TOP2APubmed: 31505165
- LCZ696 (sacubitril/valsartan) protects against cyclophosphamide-induced testicular toxicity in rats: Role of neprilysin inhibition and lncRNA TUG1 in ameliorating …Pubmed: 32197949
- Effects of different pulp-capping materials on cell death signaling pathways of lipoteichoic acid-stimulated human dental pulp stem cellsPubmed: 33206337
- Potentiation of the apoptotic signaling pathway in both the striatum and hippocampus and neurobehavioral impairment in rats exposed chronically to a low− dose of …Pubmed: 32915453
- Alogliptin attenuates cyclophosphamide-induced nephrotoxicity: a novel therapeutic approach through modulating MAP3K/JNK/SMAD3 signaling cascadePubmed: 32869669
- Potential anti-tumor activity of kefir-induced juglone and resveratrol fractions against Ehrlich ascites carcinoma-bearing BALB/c mice
- Curcumin loaded nanostructure hybrid lipid capsules for co-eradication of breast cancer and cancer stem cells with enhanced anticancer efficacy
- Effect of Graviola (Annona Muricata l.) and Ginger (Zingiber Officinale Roscoe) on Diabetes Mellitus Induced in Male Wistar Albino Rats
- The Effect of Sodium Metabisulphite on Apoptosis in the Experimental Model of Parkinson's Disease
- Cilostazol mitigates mesenteric ischemia/reperfusion-induced lung lesion: Contribution of PPAR-¦Ã, NF-¦ÊB, and STAT3 crosstalk33310046
- Potential effect of adrenomedullin on metabolic and endocrinal dysfunctions in the experimentally induced polycystic ovary: Targeting implication of endoplasmic ¡33491863
- Magnesium Isoglycyrrhizinate Alleviates Arsenic Trioxide-Induced Cardiotoxicity: Contribution of Nrf2 and TLR4/NF-¦ÊB Signaling Pathway33603344
- Potential Therapeutic Effects of New Ruthenium (III) Complex with Quercetin: Characterization, Structure, Gene Regulation, and Antitumor and Anti-Inflammatory Studies (RuIII/Q Novel Complex Is a Potent Immunoprotective Agent)
- Expression of Apoptotic Markers Bcl-2 and Bax in the Vascular Wall
- [8]‐Gingerol exerts anti‐myocardial ischemic effects in rats via modulation of the MAPK signaling pathway and L‐type Ca2+ channels34390539
- Lycopene attenuates zearalenone-induced oxidative damage of piglet sertoli cells through the nuclear factor erythroid-2 related factor signaling pathway34482067
- Allicin ameliorates renal ischemia/reperfusion injury via inhibition of oxidative stress and inflammation in rats34426252
- Galangin mitigates oxidative stress, inflammation, and apoptosis in a rat model of methotrexate hepatotoxicity34729716
- Curcumin derivative ST09 modulates the miR-199a-5p/DDR1 axis and regulates proliferation and migration in ovarian cancer cells34837026
- Isolation and characterization of anti-inflammatory and anti-proliferative compound, for B-cell Non-Hodgkin lymphoma, from Nyctanthes arbor-tristis Linn.Pubmed:35398498
- Selenium nanoparticles overcomes sorafenib resistance in thioacetamide induced hepatocellular carcinoma in rats by modulation of mTOR, NF-κB pathways and …Pubmed:35640776
- Piracetam attenuates cyclophosphamide-induced hepatotoxicity in rats: Amelioration of necroptosis, pyroptosis and caspase-dependent apoptosisPubmed:35636581
- Anti-Inflammatory, Anti-Apoptotic, and Antioxidant Roles of Honey, Royal Jelly, and Propolis in Suppressing Nephrotoxicity Induced by Doxorubicin in Male Albino …Pubmed:35624893
- Nephroprotective effect of magnesium isoglycyrrhizinate against arsenic trioxide‑induced acute kidney damage in micePubmed:35317438
- Beetroot Improves the Therapeutic Efficacy of Bone Marrow-Derived Mesenchymal Stem Cells in Preventing Cisplatin Induced Nephrotoxicity in Male Rats